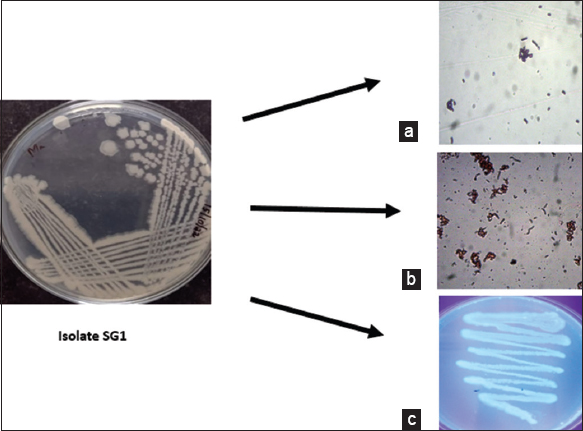
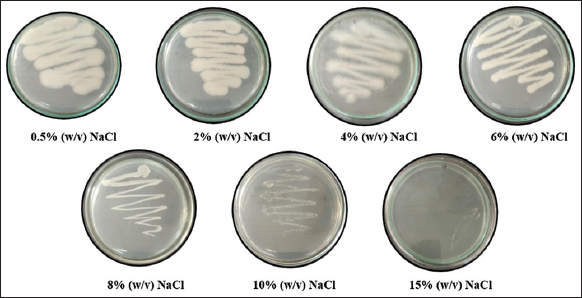

1. INTRODUCTION
The rising environmental concern over the extensive use and careless release of synthetic plastics into the biosphere has necessitated the research focus on biopolymers. Polyhydroxyalkanoates (PHA) are a class of microbial polyesters with a significant degree of biodegradability and biocompatibility [1]. They are the polymers of HA synthesized from microbes under nutrient-limited conditions [2]. The versatile material properties of PHA have made them the most promising candidate in the biomaterial industry with a wide array of applications. The search for new microbial strains from diverse environment niches is still in bloom to explore their potential in the biopolymer industry [3]. Among the PHA-producing bacteria, Bacillus spp., has received enormous attention due to their ability to utilize a wide variety of substrates as feedstock for PHA production due to their multienzyme production potential. Nevertheless, the Bacillus spp., when used for biopolymer production avoids the issues associated with lipopolysaccharide contamination that can trigger immune response in the host. Thus, the PHA extracted from them is highly biocompatible and has innumerable applications in biomedical fields ranging from bioimaging to drug delivery [4]. Although there are many reports regarding PHA production from Bacillus spp., isolated from terrestrial sources, the data regarding PHA production from Bacillus spp., isolated from marine sources are seemingly scarce in the available literature. There are several reports to prove that PHA accumulation in bacteria is enhanced under controlled stress conditions which initiates many researchers to explore the possibility of using extremophiles for PHA production [5]. Marine sources are considered to be distinct for isolation of PHA-producing bacteria as they by nature are amended with stress induced by hypersaline condition. PHA production from halotolerant organisms has multiple advantages like hypersaline conditions can prevent the contamination by nonhalophilic bacteria thus reducing the need for high-end sterilization techniques thereby minimizing the overall production cost [6]. Second, substrates and effluents with high salt concentration can be effectively tuned as fermentation media for PHA production [7]. Another advantage of employing halophilic bacteria for PHA production is the possibility of using a hypotonic lysis method for PHA recovery from bacterial biomass that can make the process more cost-effective [5]. The above-mentioned properties of PHA-producing halophilic bacteria are strictly species-specific and there are still a few reports on the degradation of PHA under increased salt concentration. Thus, careful and systematic screening is often required for the isolation and purification of PHA from halophilic and halotolerant bacteria. Taking into consideration the potential of halophilic bacteria to produce high quantities of PHA, the present work is designed to explore the possibility of isolating PHA-producing bacteria from marine sediments collected from Kerala cost followed by intensive study on their structural properties by means of analytical methods. The major objective behind this work is to add new candidates to the list of marine PHA producers in a view to make their production cost-effective and sustainable in future.
2. MATERIALS AND METHODS
2.1. Collection of Sample and Bacterial Isolation
Marine water samples were collected from the Calicut region of Kerala, India. The water samples were serially diluted and 100 μL of the sample was spread onto peptone yeast marine medium (containing [g/L]: Peptone 5, yeast extract 3, glucose 20 and agar 15) and the pH was adjusted to 7 [8]. The inoculated plates were then incubated at 37°C for 48 h. Colonies with morphologically different characteristics were selected and subcultured for further analysis.
2.2. Screening and Identification of PHA Production using the Bacterial Strains
For the qualitative screening of PHA accumulation the isolated bacterial strains were subjected to Sudan Black B [8] and Nile Blue staining [9]. Quantitative screening for PHA production was carried out in M9 minimal salt media, supplemented with 1% (w/v) glucose, 0.1% (w/v) yeast extract, and 5% (w/v) NaCl [10]. 5 mL of the overnight culture of the isolate was added to the production media and incubated at 37°C for 72 h in an incubator shaker (150 rpm). The PHA extraction was carried out using solvent extraction protocol [11]. The PHA extraction involved centrifuging the bacterial culture at 10,000 rpm for 15 min. The supernatant was discarded and the pellet obtained was suspended in 4% (w/v) sodium hypochlorite solution followed by incubation at 37°C for about 2 h. This step was done to remove the non-PHA cellular mass from the pellet. The suspension was again centrifuged and was washed with a mixture of acetone and diethyl ether in 1:1 ratio. The pellet was then dissolved in boiling chloroform and air-dried to obtain PHA biopolymer. The dry weight of the PHA was recorded and expressed in g/L [12].
2.3. Biochemical and Molecular Characterization of the most Potential Isolate
The most potential isolate giving maximum PHA yield in the quantitative test is characterized through standard biochemical test and molecular profiling using 16S ribosomal RNA (rRNA) sequencing. Molecular characterization and genomic DNA isolation of the PHA-producing bacterial isolate were carried out at Barcode Biosciences, Bengaluru, Karnataka, India. The genomic DNA from the bacteria was isolated using GeneiPure™ bacterial DNA purification kit as per the manufacturer’s protocol (Genei™, Bengaluru, India). 16S rRNA sequencing was performed using 16S rRNA-F and 16S rRNA-R primers (Universal 16S rRNA bacterial primers 27F [5’-AGAGTTTGATCCTGGCTCAG-3’] and 1392R [5’-GGTTACCTTGTTACGACTT-3’]). This forward and reverse sequencing was carried out with the forward and reverse primers using BDT v3.1 cycle sequencing kit in a thermal cycler (BioRad, USA). The 16S rRNA amplicon was sequenced in ABI 3730xl Genetic Analyzer The isolated DNA was then visualized through agarose gel electrophoresis (1% agarose). Aligner software was used for generating the consensus sequence and the basic local alignment search tool (BLAST) analysis was performed using the National Center for Biotechnology Information GenBank database. The first ten sequences were taken and aligned using CLUSTAL W, which is a multiple alignment software program, centered on maximum identity score. The distance matrix was created using the RDP database and the phylogenetic tree was established using MEGA 6 software.
2.4. Halotolerance Test
Halotolerant bacteria are those bacteria that have the capability to grow even in the absence of salt as well as in the presence of higher salt concentrations. The halotolerance of the PHA-producing isolate was done on nutrient agar plates containing 0.5% (w/v), 2% (w/v), 4% (w/v), 6% (w/v), 8% (w/v), 10% (w/v), and 15% (w/v) for 24 h at 37°C [13].
2.5. Mass Production and Extraction of PHA
M9 minimal salt media, supplemented with 1% (w/v) glucose and 0.1% (w/v) yeast extract was used for the PHA production [10]. 5 mL of the overnight culture was added to the production media and was kept for 72 h incubation at 37°C. After incubation, the PHA accumulated was harvested from the media as per the Santhanam and Sasidharan protocol [11].
2.6. Characterization of Extracted Biopolymer
2.6.1. Fourier transform infrared (FTIR) spectroscopy
FTIR is mainly used to study the functional groups present in the biopolymer [14]. For each chemical group present in the sample, distinct peaks will be formed in the IR spectrum. The infrared spectra of the PHA polymer were measured in the range of 400–4000 cm−1 using 2000 Perkins-Elmer spectrometer.
2.6.2. X-ray diffraction (XRD) analysis
XRD analysis was used to study the crystallinity of the extracted bio-polymer [15]. The extracted polymer sample was scanned at a 2θ range between 10 and 80o using a model D500 Siemens diffractometer.
2.6.3. 1H nuclear magnetic resonance (NMR) analysis
The monomeric structure of the extracted polymer was deduced through 1H NMR analysis using deuterochloroform on a Bruker Avance III spectrometer at 400 MHz [16].
2.6.4. Thermo gravimetric analysis (TGA)
TGA was performed to analyze the thermal degradation pattern and thermal stability of the biopolymer [17]. TGA was performed using TGA-DTA Perkin Elmer STA6000, Perkin Elmer Diamond. The sample was weighed and heated from a temperature range of 50°C–750°C.
2.6.5. Differential scanning calorimetry (DSC) analysis
The thermal properties and melting temperature of the extracted polymer can be deduced using DSC [18]. DSC analysis was carried out using DSC Netzsch DSC 204 F1 heat flux instrument. The sample was heated within the range of 0–300°C at the rate of 10°C/min.
3. RESULTS AND DISCUSSION
3.1. Screening for Potential PHA-Producing Marine Bacteria
In this study, 14 morphologically different bacterial strains were obtained from marine water samples collected from Calicut coastal region, Kerala, India. Screening for PHA production of the isolates was carried out qualitatively and quantitatively using PHA staining (Sudan Black and Nile Blue) and solvent precipitation method, respectively. Among the 14 isolates 3 isolates (SG1, SG2, and SG3) exhibited PHA production capability, and the isolate (SG1) that produced maximum PHA [Table 1] from modified M9 minimal salt media was selected for further study. The Gram reaction and PHA screening results of isolate ST1 are represented in Figure 1.
Table 1: PHA production from marine bacterial isolates.
| Bacterial isolate | PHA yield (g/L) |
|---|---|
| SG1 | 1.52 |
| SG2 | 1.03 |
| SG3 | 0.41 |
| Figure 1: Screening for polyhydroxyalkanoates producing isolate (a) Gram staining (b) Sudan black staining (c) Nile blue staining. [Click here to view] |
Further, the isolate SG1 was characterized through Gram staining, motility test, and standard biochemical test with 24 h of incubation, and the results are presented in Table 2. Further, 16S rRNA sequencing method was followed for the construction of a phylogenetic tree to depict the evolutionary relationship of the isolate [Figure 2]. CLUSTAL W software was employed for carrying out the multiple sequence alignment of the ten most similar hits obtained through BLAST. The phylogenetic tree constructed revealed that the PHA-producing bacteria SG1 isolated in this study has a high degree of sequence similarity (99.80%) with Bacillus subtilis. Thus, isolate SG1 was identified to be B. subtilis and the sequence was submitted to Genbank (Accession No: OP257205).
Table 2: Biochemical profile of Isolate SG1.
| Biochemical test | Results |
|---|---|
| Gram reaction | Gram positive rods |
| Motility | Motile |
| Indole test | Negative |
| Methyl red test | Negative |
| Voges proskauer test | Positive |
| Citrate utilization test | Positive |
| Catalase test | Positive |
| Oxidase test | Negative |
 | Figure 2: Phylogenetic profile of isolate SG1. [Click here to view] |
3.2. Assessment of Halotolerance Level of the Potential Isolate
A halotolerance study was carried out for the selected isolate (SG1). Nutrient agar plates supplemented with varying concentrations of NaCl ranging from 0.5% to 15% (w/v). Figure 3 shows the results of the halotolerance study from the isolated B. subtilis SG1.
| Figure 3: Halotolerance profile of Bacillus subtilis SG1. [Click here to view] |
Growth was observed till 10% (w/v) NaCl concentration. No bacterial growth was observed in the 15% (w/v) plate. Marine bacteria are capable of growing in an environment where there is an excess of carbon sources and limited amounts of nutrients like nitrogen and phosphorus [19]. Most of the halophiles can be categorized as slight, moderate, or extreme based on their halotolerance [20]. The B. subtilis OP257205 the obtained isolate showed a growth up to 10%. There are many advantages of using halophilic bacteria for PHA production. One major advantage is that the high salt concentration will actually prevent contamination by other non- halophiles as a result of which the production cost, energy, and the complexity involved in the process can be reduced. When it comes to the PHA recovery from bacteria, the cell lysis is one important factor that actually increases the production cost. The advantage of using halophiles is that such cell lysis can be carried out by simply giving a hypo-osmotic shock treatment [21]. Gunny et al., in their studies, reported that top-quality PHA biopolymers can be produced from marine conditions as they can survive in an environment with low temperature, high salinity, and low amount of organic matter [22]. Due to the high salt tolerance, metabolic and physiological capabilities, marine halophilic bacteria can actually help in developing low-cost biotechnological processes to produce various useful products [23].
3.3. Characterization of Extracted Biopolymer
3.3.1. FTIR spectroscopy
FTIR is a routinely used technique for deducing the functional groups present in the extracted biopolymer as a function of absorbance and transmittance profile. The FTIR spectrum of the extracted biopolymer [Figure 4] revealed characteristic peaks corresponding to PHA.
 | Figure 4: Fourier transform infrared spectra of the extracted biopolymer. [Click here to view] |
The major characteristic peaks obtained for the extracted biopolymer include the peaks at 3462 cm−1, 1659 cm−1, 1227 cm−1, and at 1094 cm−1. An absorption peak at 3462 cm−1 corresponds to the hydroxyl group (OH), a similar functional group band which is a characteristic feature of PHA were reported in the studies conducted by Weng et al., [24] and the strongest bands at 1659 cm−1 revealed the presence of C=O group which corresponds to ester carbonyl group [15]. Small peaks at 1227 cm−1 show the asymmetric stretching of C-O-C groups. Akdogan and Celik reported a similar kind of C-O-C stretching at 1261 cm−1 in their studies of Bacillus megaterium [18]. Peak obtained at 1094 cm−1 shows strong C-O stretching. Minute disturbances observed in the graph can be due to the impurities present in the sample. Earlier studies conducted by Vega-Castro et al., in their studies on the characterization of a PHA obtained from pineapple peel waste using Ralsthonia eutropha reported similar kinds of peaks in the range of 3200–3500 cm−1 which corresponds to OH group and the bands at 2928 cm−1 corresponds to CH vibrations of PHA [25].
3.3.2. XRD analysis
XRD study helps us to understand the nature of the extracted PHA. XRD pattern of the extracted biopolymer is shown in Figure 5. Five prominent peaks obtained here are at 27.581°, 31.839°, 45.486°, 56.567° and 66.326° respectively. The width of the peaks obtained in the XRD spectrum shows that the extracted PHA has an organized crystalline structure. The peaks obtained in this study were similar to those reported in the production of polyhydroxybutyrate (P3HB) from fish solid waste utilizing B. subtilis (KP172548) isolated from municipal sewage [26]. In their study, the prominent peaks were obtained at 13.34°, 16.96°, 21.95°, 25.92°, 27.29°, 31.77°, 45.70°, and 56.39°. The increased width of these peaks was signifying the crystalline nature of the extracted biopolymer PHB. The minor peaks at 27° indicate the partial crystalline nature of PHB [27]. PHA production from Cupriavidus necator H16 cultivated in the mineral salt medium was used to understand the change in nature of PHA from amorphous to crystalline during its formation and post extraction. Native PHA granules are formed in amorphous form inside the bacteria, which have significantly greater elasticity and flexibility than crystalline form. The fact that bacteria store PHA in an amorphous state has several significant biological implications. The mechanism that prevents the amorphous form of PHA polymers from transitioning into a thermodynamically advantageous crystalline state is still unclear. The polymer crystallizes after the stressed bacterial cells have been dried. The fact that both granule aggregation and cell drying are required to induce PHA crystallization indicates that both previously proposed hypotheses about mechanisms of amorphous PHA stabilization are correct and that both effects participate synergistically. The amorphous state of the polymer appears to be kinetically stabilized by the low rate of crystallization in the limited volume of the small PHA granules. Along with that, the water present in PHA granules appears to function as a plasticizer protecting the polymer from crystallization [28].
 | Figure 5: X-ray diffraction peaks of the extracted biopolymer. [Click here to view] |
3.3.3. 1H NMR analysis
1H NMR analysis is a routinely used technique in polymer science to understand the precise composition of the extracted polymers. In the present study, the 1H NMR analysis revealed the characteristic peaks corresponding to P3HB, one of the major classes of PHA studied all over the world. The major peaks [Figure 6] are at 1.2 ppm corresponding to methyl group, 2.5 ppm corresponding to methylene group, and 5.2 ppm signifying methane group of hydroxybutyrate (HB) [29]. In the study dealing with PHA production from distillery effluent using Bacillus endophyticus MTCC 9021, similar peaks corresponding to PHA were obtained at 1.22 ppm, 2.5 ppm, and 5.2 ppm [16]. PHA extracted from Bacillus spp. 112A revealed characteristic peaks at 1.30 ppm, 2.57 ppm, and 5.27 ppm closely correlating with the results of the present study [30].
 | Figure 6: 1H Nuclear magnetic resonance spectrum of extracted polymer. [Click here to view] |
3.3.4. TGA of extracted biopolymer
TGA was done to understand the thermal properties of the extracted biopolymer. Figure 7 represents the thermal decomposition of the PHA polymer. The sudden loss observed in the range of 50°C–100°C can be due to moisture loss. From 100°C to 377°C, a significant thermal decomposition pattern is observed, reflecting the fast pyrolysis stage. Complete degradation was not observed which can be attributed to the presence of impurities in the extracted sample. The thermal stability of the polymer was found to be higher as compared to some of the previous literature. Studies have shown that the thermal decomposition range in other Bacillus spp., is between the range of 250–300°C [31].
 | Figure 7: Thermal decomposition profile of the extracted biopolymer. [Click here to view] |
3.3.5. DSC analysis of extracted biopolymer
DSC analysis helps to gain information about the polymer stability and the polymer shelf life. The melting temperature of the extracted PHA was observed to be 107.8°C [Figure 8]. Previous literature studies for Bacillus spp. showed the melting temperature of pure PHA in a range between 130 and 170°C [32]. Here the lower melting temperature can be associated with the presence of other alkanoic compounds. Lower thermal properties can happen due to the presence of impurities or may be due to the property of the polymer produced by the microorganism [33].
 | Figure 8: Differential scanning calorimetry analysis of extracted biopolymer. [Click here to view] |
4. CONCLUSION
Biopolymer production from marine sources is an area, i.e., less explored and has extensive potential for future biomaterial research. The present study demonstrated the possibility of isolating and screening for PHA production from marine sources. The significant halotolerant property of the most potential isolate was evident from its ability to grow at a NaCl concentration up to 10% (w/v). The solvent extraction method was successful in yielding a maximum PHA yield of about 1.59 g/L. The study also revealed an in-depth characterization of the polymer using sophisticated instrumentation techniques like FTIR, NMR, XRD, TGA, and DSC to understand the monomeric composition and thermal behavior of the polymer. Further investigation to optimize the media components for enhanced PHA production using statistical methods and biocompatibility testing using cell line studies are future prospects of the current research work.
5. ACKNOWLEDGMENT
Authors extend their gratitude to Barcode Biosciences, Bengaluru, Karnataka, India, for providing 16S rRNA Sequencing facility.
6. AUTHORS’ CONTRIBUTIONS
Sneha Grigray was involved in data curation, formal analysis, and manuscript preparation. Mridul Umesh and Vellingiri Manon Mani were involved in the conceptualization, data analysis, manuscript preparation, proofreading, and editing of the manuscript.
7. FUNDING
There is no funding to report with regard to this research work.
8. CONFLICTS OF INTEREST
The authors report no financial or any other conflicts of interest related to this work.
9. ETHICAL APPROVALS
This study does not involve experiments on animals or human subjects.
10. DATA AVAILABILITY
All data generated and analyzed are included in this research article.
11. PUBLISHER’S NOTE
This journal remains neutral with regard to jurisdictional claims in published institutional affiliation.
REFERENCES
1. Umesh M, Mani VM, Thazeem B, Preethi K. Statistical optimization of process parameters for bioplastic (PHA) Production by Bacillus subtilis NCDC0671 using orange peel-based medium. Iran J Sci Technol Transac A Sci 2017;42:1947-55. [https://doi.org/10.1007/s40995-017-0457-9]
2. Kumar V, Lakkaboyana SK, Tsouko E, Maina S, Pandey M, Umesh M, et al. Commercialization potential of agro-based polyhydroxyalkanoates biorefinery:A technical perspective on advances and critical barriers. Int J Biol Macromol 2023;234:123733. [https://doi.org/10.1016/j.ijbiomac.2023.123733]
3. Saravanan K, Umesh M, Kathirvel P. Microbial polyhydroxyalkanoates (PHAs):A review on biosynthesis, properties, fermentation strategies and its prospective applications for sustainable future. J Polym Environ 2022;30:4903-35. [https://doi.org/10.1007/s10924-022-02562-7]
4. Umesh M, Priyanka K, Thazeem B, Preethi K. Biogenic PHA nanoparticle synthesis and characterization from Bacillus subtilis NCDC0671 using orange peel medium. Int J Polym Mater Polym Biomater 2018;67:996-1004. [https://doi.org/10.1080/00914037.2017.1417284]
5. Obruca S, Sedlacek P, Koller M. The underexplored role of diverse stress factors in microbial biopolymer synthesis. Bioresour Technol 2021;326:124767. [https://doi.org/10.1016/j.biortech.2021.124767]
6. Chen GQ, Jiang XR. Next generation industrial biotechnology based on extremophilic bacteria. Curr Opin Biotechnol 2018;50:94-100. [https://doi.org/10.1016/j.copbio.2017.11.016]
7. Dietrich K, Dumont MJ, Del Rio LF, Orsat V. Sustainable PHA production in integrated lignocellulose biorefineries. N Biotechnol 2019;49:161-8. [https://doi.org/10.1016/j.nbt.2018.11.004]
8. López-Cortés A, Lanz-Landázuri A, García-Maldonado JQ. Screening and isolation of PHB-producing bacteria in a polluted marine microbial mat. Microb Ecol 2008;56:112-20. [https://doi.org/10.1007/s00248-007-9329-8]
9. Kitamura S, Doi Y. Staining method of poly(3-hydroxyalkanoic acids) producing bacteria by nile blue. Biotechnol Tech 1994;8:345-50. [https://doi.org/10.1007/BF02428979]
10. Hong JW, Song HS, Moon YM, Hong YG, Bhatia SK, Jung HR, et al. Polyhydroxybutyrate production in halophilic marine bacteria Vibrio proteolyticus isolated from the Korean Peninsula. Bioprocess Biosyst Eng 2019;42:603-10.
11. Santhanam A, Sasidharan S. Microbial production of polyhydroxyalkanotes (PHA)from Alcaligens spp. and Pseudomonas oleovorans using different carbon sources. Afr J Biotechnol 2010;9:3144-50.
12. Vijay R, Tarika K. Microbial production of polyhydroxyalkanoates (Phas) using kitchen waste as an inexpensive carbon source. Biosci Biotechnol Res Asia 2019;16:155-66. [https://doi.org/10.13005/bbra/2733]
13. Roberts MF. Organic compatible solutes of halotolerant and halophilic microorganisms. Saline Syst 2005;1:5. [https://doi.org/10.1186/1746-1448-1-5]
14. Pandian SR, Deepak V, Kalishwaralal K, Rameshkumar N, Jeyaraj M, Gurunathan S. Optimization and fed-batch production of PHB utilizing dairy waste and sea water as nutrient sources by Bacillus megaterium SRKP-3. Bioresour Technol 2010;101:705-11. [https://doi.org/10.1016/j.biortech.2009.08.040]
15. Rao A, Haque S, El-Enshasy HA, Singh V, Mishra BN. RSM GA based optimization of bacterial PHA production and in silico modulation of citrate synthase for enhancing PHA production. Biomolecules 2019;9:872. [https://doi.org/10.3390/biom9120872]
16. Priyanka K, Umesh M, Thazeem B, Preethi K. Polyhydroxyalkanoate biosynthesis and characterization from optimized medium utilizing distillery effluent using Bacillus endophyticus MTCC 9021:A statistical approach. Biocatal Biotransform 2021;39:16-28. [https://doi.org/10.1080/10242422.2020.1789112]
17. Mascarenhas J, Aruna K. Characterization of polyhydroxyalkaonoate extracted from Bacillus megaterium JHA and its biodegradation studies. J Appl Biotechnol Reports 2021;8:346-60. [https://doi.org/10.9734/bpi/mono/978-93-90516-16-2]
18. Akdogan M, Çelik E. Purification and characterization of polyhydroxyalkanoate (PHA) from a Bacillus megaterium strain using various dehydration techniques. J Chem Technol Biotechnol 2018;93:2292-8. [https://doi.org/10.1002/jctb.5572]
19. Moorkoth D, Nampoothiri KM. Production and characterization of poly(3-hydroxy butyrate-co-3 hydroxyvalerate) (PHBV) by a novel halotolerant mangrove isolate. Bioresour Technol 2016;201:253-60. [https://doi.org/10.1016/j.biortech.2015.11.046]
20. Ollivier B, Caumette P, Garcia JL, Mah RA. Anaerobic bacteria from hypersaline environments. Microbiol Rev 1994;58:27-38. [https://doi.org/10.1128/mr.58.1.27-38.1994]
21. Quillaguamán J, Guzmán H, Van-Thuoc D, Hatti-Kaul R. Synthesis and production of polyhydroxyalkanoates by halophiles:Current potential and future prospects. Appl Microbiol Biotechnol 2010;85:1687-96. [https://doi.org/10.1007/s00253-009-2397-6]
22. Gunny AA, Arbain D, Jamal P, Gumba RE. Improvement of halophilic cellulase production from locally isolated fungal strain. Saudi J Biol Sci 2015;22:476-83. [https://doi.org/10.1016/j.sjbs.2014.11.021]
23. Gnaim R, Polikovsky M, Unis R, Sheviryov J, Gozin M, Golberg A. Marine bacteria associated with the green seaweed Ulva sp. for the production of polyhydroxyalkanoates. Bioresour Technol 2021;328:124815. [https://doi.org/10.1016/j.biortech.2021.124815]
24. Weng YX, Wang XL, Wang YZ. Biodegradation behavior of PHAs with different chemical structures under controlled composting conditions. Polym Test 2011;30:372-80. [https://doi.org/10.1016/j.polymertesting.2011.02.001]
25. Vega-Castro O, Contreras-Calderon J, León E, Segura A, Arias M, Pérez L, et al. Characterization of a polyhydroxyalkanoate obtained from pineapple peel waste using Ralsthonia eutropha. J Biotechnol 2016;231:232-8. [https://doi.org/10.1016/j.jbiotec.2016.06.018]
26. Mohapatra S, Sarkar B, Samantaray DP, Daware A, Maity S, Pattnaik S, et al. Bioconversion of fish solid waste into PHB using Bacillus subtilis based submerged fermentation process. Environ Technol 2017;38:3201-8. [https://doi.org/10.1080/09593330.2017.1291759]
27. Sun X, Guo L, Sato H, Ozaki Y, Yan S, Takahashi I. A study on the crystallization behavior of poly(b-hydroxybutyrate) thin films on Si wafers. Polymer 2011;52:3865-70. [https://doi.org/10.1016/j.polymer.2011.06.024]
28. Sedlacek P, Slaninova E, Enev V, Koller M, Nebesarova J, Marova I, et al. What keeps polyhydroxyalkanoates in bacterial cells amorphous? A derivation from stress exposure experiments. Appl Microbiol Biotechnol 2019;103:1905-17. [https://doi.org/10.1007/s00253-018-09584-z]
29. Mridul U, Sreehari S, Suma S, Sankar SA. A sustainable approach for fish waste valorization through polyhydroxyalkanoate production by Bacillus megaterium NCDC0679 and its optimization studies. In:Biomass Conversion and Biorefinery. Berlin:Springer;2022.
30. Thirumala M, Reddy SV, Mahmood SK. Production and characterization of PHB from two novel strains of Bacillus spp. isolated from soil and activated sludge. J Ind Microbiol Biotechnol 2010;37:271-8. [https://doi.org/10.1007/s10295-009-0670-4]
31. Israni N, Shivakumar S. Polyhydroxyalkanoate (PHA) biosynthesis from directly valorized ragi husk and sesame oil cake by Bacillus megaterium strain Ti3:Statistical optimization and characterization. Int J Biol Macromol 2020;148:20-30. [https://doi.org/10.1016/j.ijbiomac.2020.01.082]
32. Ashraf H, Iqbal J, Qadeer MA. Production of alpha amylase by Bacillus licheniformis using an economical medium. Bioresour Technol 2003;87:57-61. [https://doi.org/10.1016/S0960-8524(02)00198-0]
33. Rodríguez-Contreras A, Koller M, Miranda-de Sousa Dias M, Calafell-Monfort M, Braunegg G, Marqués-Calvo MS. High production of poly(3-hydroxybutyrate) from a wild Bacillus megaterium Bolivian strain. J Appl Microbiol 2013;114:1378-87. [https://doi.org/10.1111/jam.12151]